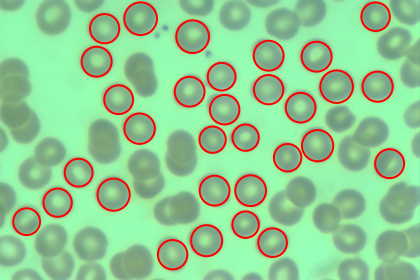

Application Areas
Analyze Segmented Cells
Use blob analysis techniques on a segmented image to to mark the location and size of complete and non-overlapping cells in a microscopic image.
| In[1]:= |  X |
| In[2]:= |  X |
| Out[2]= |  |
| New in Wolfram Mathematica 8: Comprehensive Image Processing Environment | ◄ previous | next ► |
| In[1]:= |  X |
| In[2]:= |  X |
| Out[2]= | |